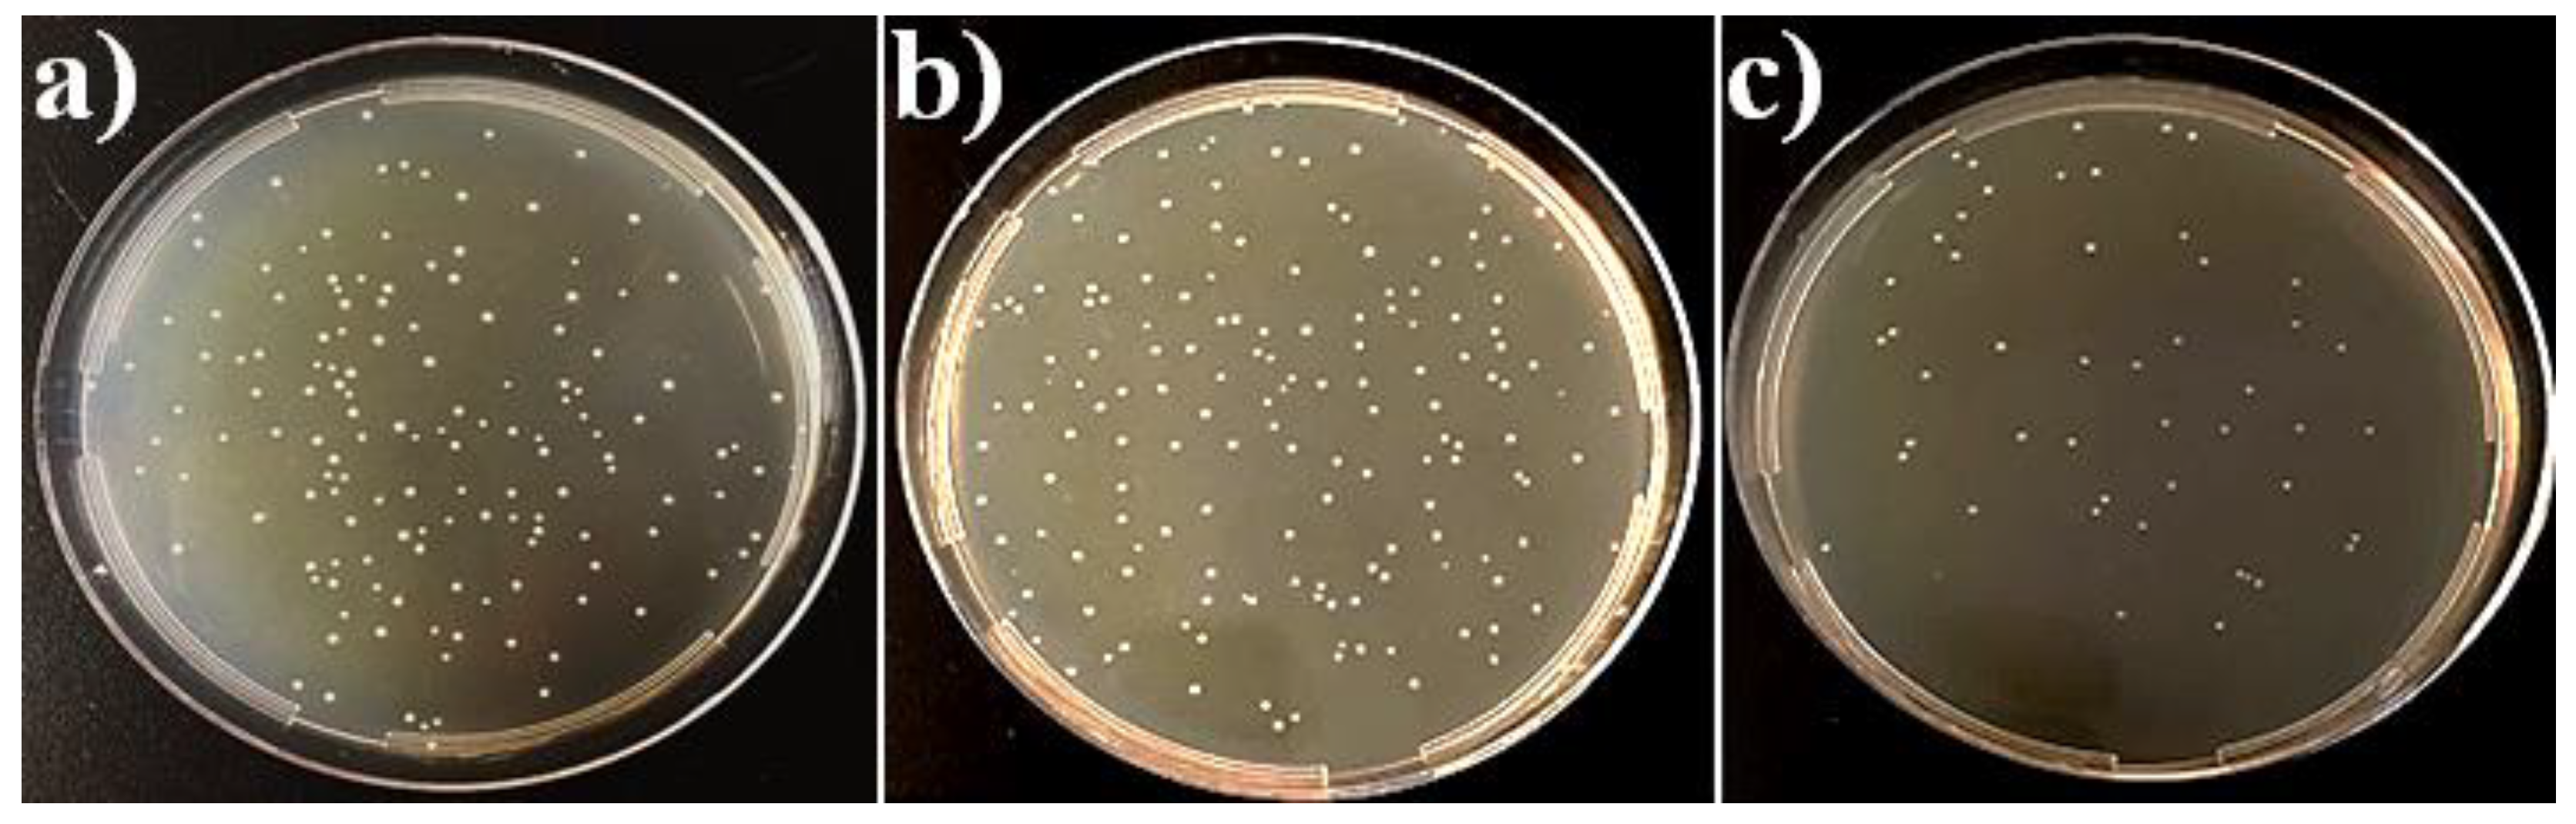
Coatings 09 00001 g008
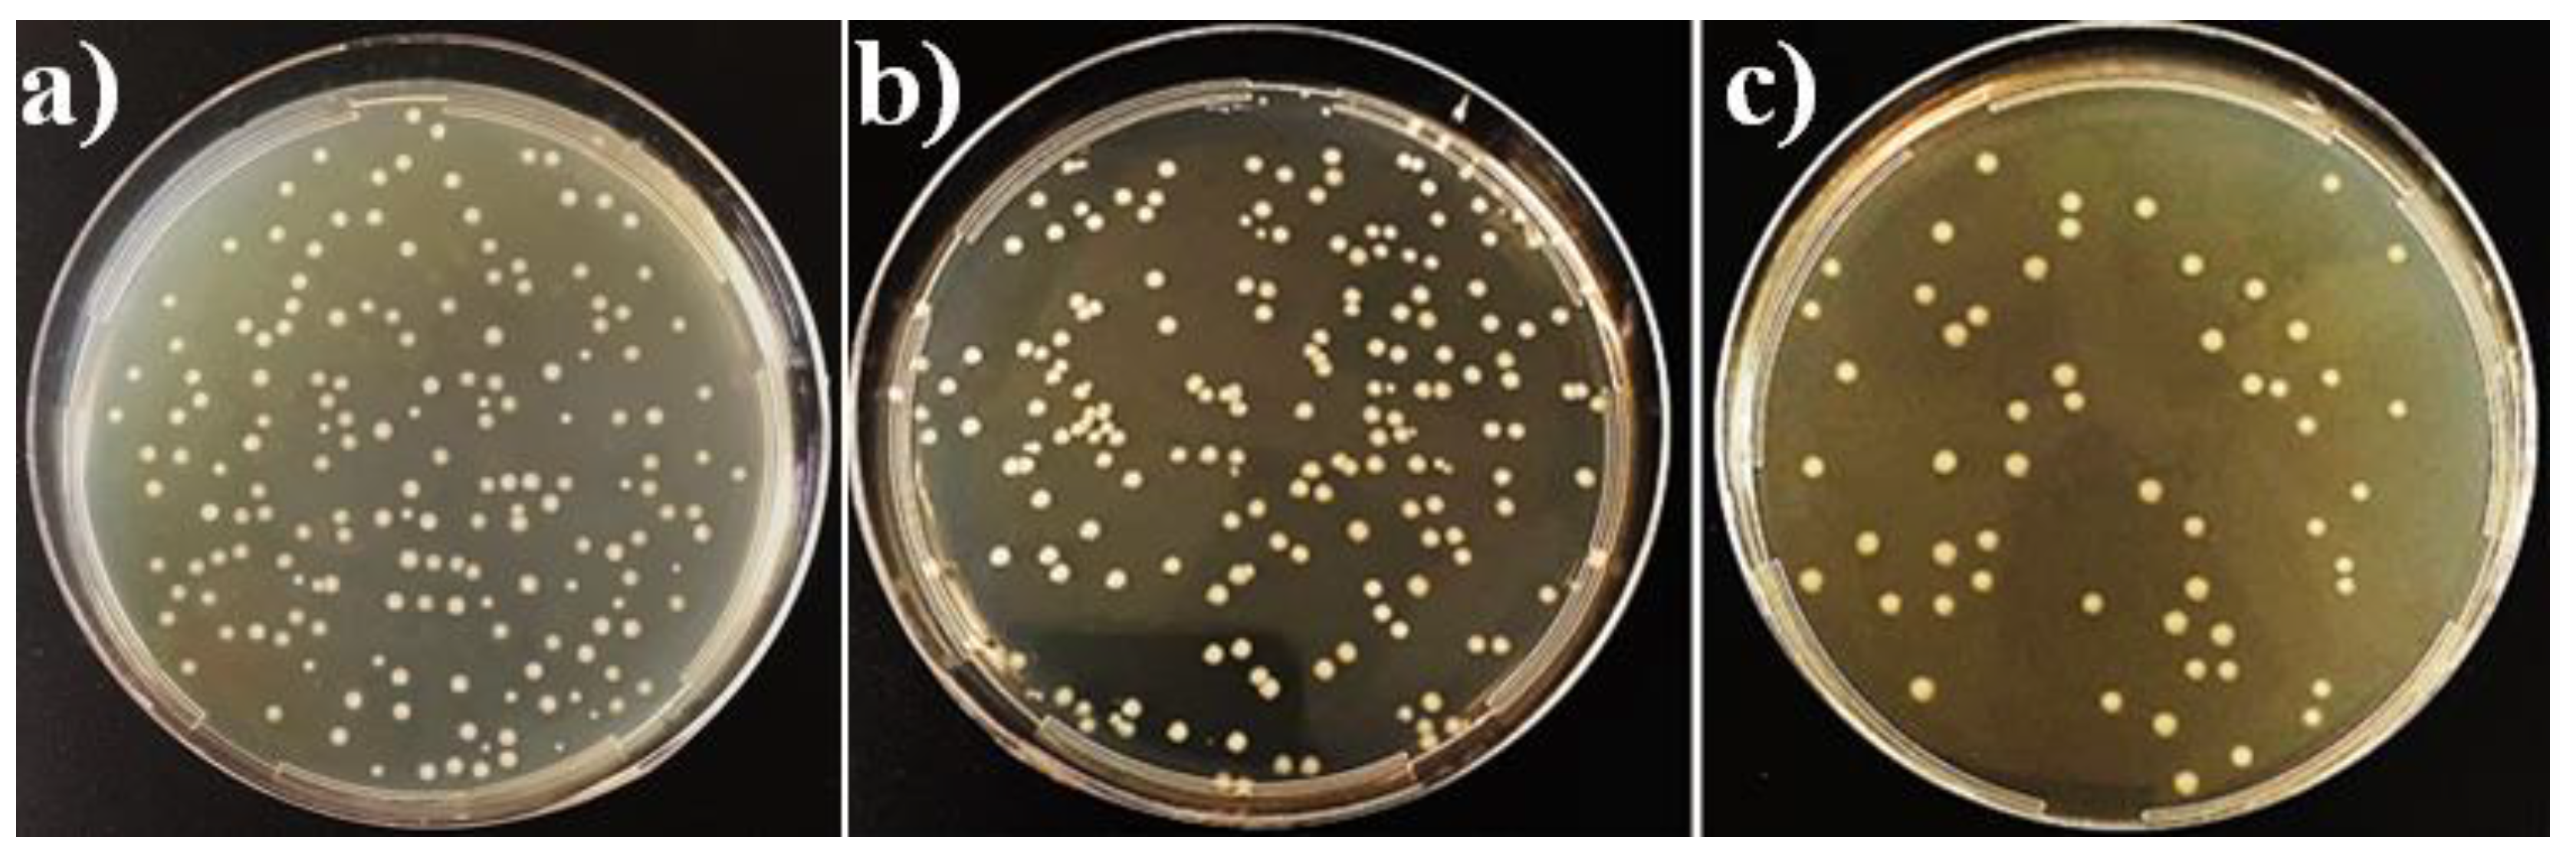
Coatings 09 00001 g009

Characterization, Bioactivity and Antibacterial Properties of Copper-Based TiO2 Bioceramic Coatings Fabricated on Titanium
Abstract
:1. Introduction
2. Materials and Methods
2.1. Sample Preparation
2.2. Micro Arc Oxidation (MAO) Process
2.3. Physical Vapor Deposition-Thermal Evaporation (PVD-TE) Process
2.4. Characterization of the Coatings
2.5. In Vitro Bioactivity Tests
2.6. In Vitro Antibacterial Activity of the Coatings
3. Results and Discussion
3.1. Phase Structures of the Coatings
3.2. Surface Structures of the Coatings
3.3. Elemental Chemical Analysis of the Coatings
3.4. Wettability of the Coatings
3.5. In Vitro Bioactivity of the Coatings
3.6. In Vitro Antibacterial Activity of the Coatings
4. Conclusions
Funding
Acknowledgments
Conflicts of Interest
References
- Quintero, D.; Galvis, O.; Calderón, J.A.; Castaño, J.G.; Echeverría, F. Effect of electrochemical parameters on the formation of anodic films on commercially pure titanium by plasma electrolytic oxidation. Surf. Coat. Technol. 2014, 258, 1223–1231. [Google Scholar] [CrossRef]
- Yang, W.; Xu, D.; Guo, Q.; Chen, T.; Chen, J. Influence of electrolyte composition on microstructure and properties of coatings formed on pure Ti substrate by micro arc oxidation. Surf. Coat. Technol. 2018, 349, 522–528. [Google Scholar] [CrossRef]
- Teker, D.; Muhaffel, F.; Menekse, M.; Karaguler, N.G.; Baydogan, M.; Cimenoglu, H. Characteristics of multi-layer coating formed on commercially pure titanium for biomedical applications. Mater. Sci. Eng. C 2015, 48, 579–585. [Google Scholar] [CrossRef] [PubMed]
- Liu, J.-X.; Yang, D.-Z.; Shi, F.; Cai, Y.-J. Sol–gel deposited TiO2 film on NiTi surgical alloy for biocompatibility improvement. Thin Solid Films 2003, 429, 225–230. [Google Scholar] [CrossRef]
- Duarte, L.T.; Bolfarini, C.; Biaggio, S.R.; Rocha-Filho, R.C.; Nascente, P.A.P. Growth of aluminum-free porous oxide layers on titanium and its alloys Ti-6Al-4V and Ti-6Al-7Nb by micro-arc oxidation. Mater. Sci. Eng. C 2014, 41, 343–348. [Google Scholar] [CrossRef] [PubMed]
- Terleeva, O.P.; Sharkeev, Y.P.; Slonova, A.I.; Mironov, I.V.; Legostaeva, E.V.; Khlusov, I.A.; Matykina, E.; Skeldon, P.; Thompson, G.E. Effect of microplasma modes and electrolyte composition on micro-arc oxidation coatings on titanium for medical applications. Surf. Coat. Technol. 2010, 205, 1723–1729. [Google Scholar] [CrossRef]
- Yoon, I.-K.; Hwang, J.-Y.; Jang, W.-C.; Kim, H.-W.; Shin, U.S. Natural bone-like biomimetic surface modification of titanium. Appl. Surf. Sci. 2014, 301, 401–409. [Google Scholar] [CrossRef]
- Albrektsson, T.; Jacobsson, M. Bone-metal interface in osseointegration. J. Prosthet. Dent. 1987, 57, 597–607. [Google Scholar] [CrossRef]
- Venkateswarlu, K.; Rameshbabu, N.; Sreekanth, D.; Bose, A.C.; Muthupandi, V.; Subramanian, S. Fabrication and characterization of micro-arc oxidized fluoride containing titania films on cp Ti. Ceram. Int. 2013, 39, 801–812. [Google Scholar] [CrossRef]
- Durdu, S.; Usta, M.; Berkem, A.S. Bioactive coatings on Ti6Al4V alloy formed by plasma electrolytic oxidation. Surf. Coat. Technol. 2016, 301, 85–93. [Google Scholar] [CrossRef]
- Drnovšek, N.; Rade, K.; Milačič, R.; Štrancar, J.; Novak, S. The properties of bioactive TiO2 coatings on Ti-based implants. Surf. Coat. Technol. 2012, 209, 177–183. [Google Scholar] [CrossRef]
- He, X.; Zhang, G.; Wang, X.; Hang, R.; Huang, X.; Qin, L.; Tang, B.; Zhang, X. Biocompatibility, corrosion resistance and antibacterial activity of TiO2/CuO coating on titanium. Ceram. Int. 2017, 43, 16185–16195. [Google Scholar] [CrossRef]
- Çomaklı, O.; Yazıcı, M.; Kovacı, H.; Yetim, T.; Yetim, A.F.; Çelik, A. Tribological and electrochemical properties of TiO2 films produced on cp-Ti by sol-gel and silar in bio-simulated environment. Surf. Coat. Technol. 2018, 352, 513–521. [Google Scholar] [CrossRef]
- Uhm, S.-H.; Song, D.-H.; Kwon, J.-S.; Im, S.-Y.; Han, J.-G.; Kim, K.-N. Time-dependent growth of TiO2 nanotubes from a magnetron sputtered Ti thin film. Thin Solid Films 2013, 547, 181–187. [Google Scholar] [CrossRef]
- Garcia-Valenzuela, A.; Alvarez, R.; Rico, V.; Cotrino, J.; Gonzalez-Elipe, A.R.; Palmero, A. Growth of nanocolumnar porous TiO2 thin films by magnetron sputtering using particle collimators. Surf. Coat. Technol. 2018, 343, 172–177. [Google Scholar] [CrossRef]
- Cabanas-Polo, S.; Boccaccini, A.R. Electrophoretic deposition of nanoscale TiO2: Technology and applications. J. Eur. Ceram. Soc. 2016, 36, 265–283. [Google Scholar] [CrossRef]
- An, S.-H.; Matsumoto, T.; Miyajima, H.; Sasaki, J.-I.; Narayanan, R.; Kim, K.-H. Surface characterization of alkali- and heat-treated Ti with or without prior acid etching. Appl. Surf. Sci. 2012, 258, 4377–4382. [Google Scholar] [CrossRef]
- Kim, S.-Y.; Kim, Y.-K.; Jang, Y.-S.; Park, I.-S.; Lee, S.-J.; Jeon, J.-G.; Lee, M.-H. Bioactive effect of alkali-heat treated TiO2 nanotubes by water or acid treatment. Surf. Coat. Technol. 2016, 303, 256–267. [Google Scholar] [CrossRef]
- Weng, F.; Chen, C.; Yu, H. Research status of laser cladding on titanium and its alloys: A review. Mater. Des. 2014, 58, 412–425. [Google Scholar] [CrossRef]
- Sharifi, N.; Pugh, M.; Moreau, C.; Dolatabadi, A. Developing hydrophobic and superhydrophobic TiO2 coatings by plasma spraying. Surf. Coat. Technol. 2016, 289, 29–36. [Google Scholar] [CrossRef]
- Wang, H.-D.; He, P.-F.; Ma, G.-Z.; Xu, B.-S.; Xing, Z.-G.; Chen, S.-Y.; Liu, Z.; Wang, Y.-W. Tribological behavior of plasma sprayed carbon nanotubes reinforced TiO2 coatings. J. Eur. Ceram. Soc. 2018, 38, 3660–3672. [Google Scholar] [CrossRef]
- Zhou, R.; Wei, D.; Cheng, S.; Li, B.; Wang, Y.; Jia, D.; Zhou, Y.; Guo, H. The structure and in vitro apatite formation ability of porous titanium covered bioactive microarc oxidized TiO2-based coatings containing Si, Na and Ca. Ceram. Int. 2014, 40, 501–509. [Google Scholar] [CrossRef]
- Durdu, S.; Usta, M. The tribological properties of bioceramic coatings produced on Ti6Al4V alloy by plasma electrolytic oxidation. Ceram. Int. 2014, 40, 3627–3635. [Google Scholar] [CrossRef]
- Du, Q.; Wei, D.; Wang, Y.; Cheng, S.; Liu, S.; Zhou, Y.; Jia, D. The effect of applied voltages on the structure, apatite-inducing ability and antibacterial ability of micro arc oxidation coating formed on titanium surface. Bioact. Mater. 2018, 3, 426–433. [Google Scholar] [CrossRef] [PubMed]
- He, Y.; Zhang, Y.; Shen, X.; Tao, B.; Liu, J.; Yuan, Z.; Cai, K. The fabrication and in vitro properties of antibacterial polydopamine-ll-37-POPC coatings on micro-arc oxidized titanium. Colloids Surf. B Biointerfaces 2018, 170, 54–63. [Google Scholar] [CrossRef] [PubMed]
- Sun, L.; Berndt, C.C.; Gross, K.A.; Kucuk, A. Material fundamentals and clinical performance of plasma-sprayed hydroxyapatite coatings: A review. J. Biomed. Mater. Res. 2001, 58, 570–592. [Google Scholar] [CrossRef] [PubMed]
- Manso, M.; Jiménez, C.; Morant, C.; Herrero, P.; Martínez-Duart, J.M. Electrodeposition of hydroxyapatite coatings in basic conditions. Biomaterials 2000, 21, 1755–1761. [Google Scholar] [CrossRef]
- Lee, J.-H.; Kim, H.-E.; Shin, K.-H.; Koh, Y.-H. Electrodeposition of biodegradable sol-gel derived silica onto nanoporous TiO2 surface formed on Ti substrate. Mater. Lett. 2011, 65, 1519–1521. [Google Scholar] [CrossRef]
- Xu, L.; Wu, C.; Lei, X.; Zhang, K.; Liu, C.; Ding, J.; Shi, X. Effect of oxidation time on cytocompatibility of ultrafine-grained pure Ti in micro-arc oxidation treatment. Surf. Coat. Technol. 2018, 342, 12–22. [Google Scholar] [CrossRef]
- Yilmaz, M.S.; Sahin, O. Applying high voltage cathodic pulse with various pulse durations on aluminium via micro-arc oxidation (MAO). Surf. Coat. Technol. 2018, 347, 278–285. [Google Scholar] [CrossRef]
- Yang, W.; Xu, D.; Yao, X.; Wang, J.; Chen, J. Stable preparation and characterization of yellow micro arc oxidation coating on magnesium alloy. J. Alloy. Compd. 2018, 745, 609–616. [Google Scholar] [CrossRef]
- Yang, W.; Xu, D.; Wang, J.; Yao, X.; Chen, J. Microstructure and corrosion resistance of micro arc oxidation plus electrostatic powder spraying composite coating on magnesium alloy. Corros. Sci. 2018, 136, 174–179. [Google Scholar] [CrossRef]
- Zhang, D.; Ge, Y.; Liu, G.; Gao, F.; Li, P. Investigation of tribological properties of micro-arc oxidation ceramic coating on Mg alloy under dry sliding condition. Ceram. Int. 2018, 44, 16164–16172. [Google Scholar] [CrossRef]
- Zhang, J.; Fan, Y.; Zhao, X.; Ma, R.; Du, A.; Cao, X. Influence of duty cycle on the growth behavior and wear resistance of micro-arc oxidation coatings on hot dip aluminized cast iron. Surf. Coat. Technol. 2018, 337, 141–149. [Google Scholar] [CrossRef]
- Cui, L.-Y.; Liu, H.-P.; Zhang, W.-L.; Han, Z.-Z.; Deng, M.-X.; Zeng, R.-C.; Li, S.-Q.; Wang, Z.-L. Corrosion resistance of a superhydrophobic micro-arc oxidation coating on Mg-4Li-1Ca alloy. J. Mater. Sci. Technol. 2017, 33, 1263–1271. [Google Scholar] [CrossRef]
- Fan, X.; Feng, B.; Di, Y.; Lu, X.; Duan, K.; Wang, J.; Weng, J. Preparation of bioactive TiO film on porous titanium by micro-arc oxidation. Appl. Surf. Sci. 2012, 258, 7584–7588. [Google Scholar] [CrossRef]
- Zhang, C.L.; Zhang, F.; Song, L.; Zeng, R.C.; Li, S.Q.; Han, E.H. Corrosion resistance of a superhydrophobic surface on micro-arc oxidation coated Mg-Li-Ca alloy. J. Alloy. Compd. 2017, 728, 815–826. [Google Scholar] [CrossRef]
- Wang, Y.; Yu, H.; Chen, C.; Zhao, Z. Review of the biocompatibility of micro-arc oxidation coated titanium alloys. Mater. Des. 2015, 85, 640–652. [Google Scholar] [CrossRef]
- Wang, L.; Shi, L.; Chen, J.; Shi, Z.; Ren, L.; Wang, Y. Biocompatibility of Si-incorporated TiO2 film prepared by micro-arc oxidation. Mater. Lett. 2014, 116, 35–38. [Google Scholar] [CrossRef]
- Li, Y.; Wang, W.; Liu, H.; Lei, J.; Zhang, J.; Zhou, H.; Qi, M. Formation and in vitro/in vivo performance of “cortex-like” micro/nano-structured TiO2 coatings on titanium by micro-arc oxidation. Mater. Sci. Eng. C 2018, 87, 90–103. [Google Scholar] [CrossRef]
- Liu, X.Y.; Chu, P.K.; Ding, C.X. Surface modification of titanium, titanium alloys, and related materials for biomedical applications. Mater. Sci. Eng. R-Rep. 2004, 47, 49–121. [Google Scholar] [CrossRef] [Green Version]
- Wu, Q.J.; Li, J.H.; Zhang, W.J.; Qian, H.X.; She, W.J.; Pan, H.Y.; Wen, J.; Zhang, X.L.; Liu, X.Y.; Jiang, X.Q. Antibacterial property, angiogenic and osteogenic activity of Cu-incorporated TiO2 coating. J. Mater. Chem. B 2014, 2, 6738–6748. [Google Scholar] [CrossRef]
- Durdu, S.; Aktug, S.L.; Korkmaz, K.; Yalcin, E.; Aktas, S. Fabrication, characterization and in vitro properties of silver-incorporated TiO2 coatings on titanium by thermal evaporation and micro-arc oxidation. Surf. Coat. Technol. 2018, 352, 600–608. [Google Scholar] [CrossRef]
- Hu, H.; Zhang, W.; Qiao, Y.; Jiang, X.; Liu, X.; Ding, C. Antibacterial activity and increased bone marrow stem cell functions of Zn-incorporated TiO2 coatings on titanium. Acta Biomater. 2012, 8, 904–915. [Google Scholar] [CrossRef] [PubMed]
- Yao, X.; Zhang, X.; Wu, H.; Tian, L.; Ma, Y.; Tang, B. Microstructure and antibacterial properties of Cu-doped TiO2 coating on titanium by micro-arc oxidation. Appl. Surf. Sci. 2014, 292, 944–947. [Google Scholar] [CrossRef]
- Wu, C.; Zhou, Y.; Xu, M.; Han, P.; Chen, L.; Chang, J.; Xiao, Y. Copper-containing mesoporous bioactive glass scaffolds with multifunctional properties of angiogenesis capacity, osteostimulation and antibacterial activity. Biomaterials 2013, 34, 422–433. [Google Scholar] [CrossRef] [PubMed]
- Li, J.; Zhai, D.; Lv, F.; Yu, Q.; Ma, H.; Yin, J.; Yi, Z.; Liu, M.; Chang, J.; Wu, C. Preparation of copper-containing bioactive glass/eggshell membrane nanocomposites for improving angiogenesis, antibacterial activity and wound healing. Acta Biomater. 2016, 36, 254–266. [Google Scholar] [CrossRef]
- Matsumoto, N.; Sato, K.; Yoshida, K.; Hashimoto, K.; Toda, Y. Preparation and characterization of β-tricalcium phosphate Co-doped with monovalent and divalent antibacterial metal ions. Acta Biomater. 2009, 5, 3157–3164. [Google Scholar] [CrossRef]
- Zhang, X.; Huang, X.; Ma, Y.; Lin, N.; Fan, A.; Tang, B. Bactericidal behavior of Cu-containing stainless steel surfaces. Appl. Surf. Sci. 2012, 258, 10058–10063. [Google Scholar] [CrossRef]
- Ruparelia, J.P.; Chatterjee, A.K.; Duttagupta, S.P.; Mukherji, S. Strain specificity in antimicrobial activity of silver and copper nanoparticles. Acta Biomater. 2008, 4, 707–716. [Google Scholar] [CrossRef] [Green Version]
- Huang, Q.; Liu, X.; Zhang, R.; Yang, X.; Lan, C.; Feng, Q.; Liu, Y. The development of Cu-incorporated micro/nano-topographical bio-ceramic coatings for enhanced osteoblast response. Appl. Surf. Sci. 2019, 465, 575–583. [Google Scholar] [CrossRef]
- Zhu, W.; Zhang, Z.X.; Gu, B.B.; Sun, J.Y.; Zhu, L.X. Biological activity and antibacterial property of nano-structured TiO2 coating incorporated with Cu prepared by micro-arc oxidation. J. Mater. Sci. Technol. 2013, 29, 237–244. [Google Scholar] [CrossRef]
- Zhang, X.; Li, J.; Wang, X.; Wang, Y.; Hang, R.; Huang, X.; Tang, B.; Chu, P.K. Effects of copper nanoparticles in porous TiO2 coatings on bacterial resistance and cytocompatibility of osteoblasts and endothelial cells. Mater. Sci. Eng. C 2018, 82, 110–120. [Google Scholar] [CrossRef] [PubMed]
- Huang, Q.; Li, X.; Elkhooly, T.A.; Liu, X.; Zhang, R.; Wu, H.; Feng, Q.; Liu, Y. The Cu-containing TiO2 coatings with modulatory effects on macrophage polarization and bactericidal capacity prepared by micro-arc oxidation on titanium substrates. Colloids Surf. B Biointerfaces 2018, 170, 242–250. [Google Scholar] [CrossRef] [PubMed]
- Zhang, L.; Guo, J.Q.; Huang, X.Y.; Zhang, Y.N.; Han, Y. The dual function of Cu-doped TiO2 coatings on titanium for application in percutaneous implants. J. Mater. Chem. B 2016, 4, 3788–3800. [Google Scholar] [CrossRef]
- Wu, H.B.; Zhang, X.Y.; Geng, Z.H.; Yin, Y.; Hang, R.Q.; Huang, X.B.; Yao, X.H.; Tang, B. Preparation, antibacterial effects and corrosion resistant of porous Cu-TiO2 coatings. Appl. Surf. Sci. 2014, 308, 43–49. [Google Scholar] [CrossRef]
- Kokubo, T.; Takadama, H. How useful is SBF in predicting in vivo bone bioactivity? Biomaterials 2006, 27, 2907–2915. [Google Scholar] [CrossRef] [PubMed]
- Wang, Y.M.; Jiang, B.L.; Lei, T.Q.; Guo, L.X. Dependence of growth features of microarc oxidation coatings of titanium alloy on control modes of alternate pulse. Mater. Lett. 2004, 58, 1907–1911. [Google Scholar] [CrossRef]
- Hanaor, D.A.H.; Sorrell, C.C. Review of the anatase to rutile phase transformation. J. Mater. Sci. 2011, 46, 855–874. [Google Scholar] [CrossRef]
- Yerokhin, A.L.; Nie, X.; Leyland, A.; Matthews, A. Characterisation of oxide films produced by plasma electrolytic oxidation of a Ti–6Al–4V alloy. Surf. Coat. Technol. 2000, 130, 195–206. [Google Scholar] [CrossRef]
- Li, Z.W.; Di, S.C. Microstructure and properties of MAO composite coatings containing nanorutile TiO2 particles. Surf. Rev. Lett. 2017, 24, 1750115. [Google Scholar] [CrossRef]
- Yerokhin, L.; Snizhko, L.O.; Gurevina, N.L.; Leyland, A.; Pilkington, A.; Matthews, A. Discharge characterization in plasma electrolytic oxidation of aluminium. J. Phys. D-Appl. Phys. 2003, 36, 2110–2120. [Google Scholar] [CrossRef]
- Cimenoglu, H.; Gunyuz, M.; Kose, G.T.; Baydogan, M.; Ugurlu, F.; Sener, C. Micro-arc oxidation of Ti6Al4V and Ti6Al7Nb alloys for biomedical applications. Mater. Charact. 2011, 62, 304–311. [Google Scholar] [CrossRef]
- Deng, F.L.; Zhang, W.Z.; Zhang, P.F.; Liu, C.H.; Ling, J.Q. Improvement in the morphology of micro-arc oxidised titanium surfaces: A new process to increase osteoblast response. Mater. Sci. Eng. C-Mater. Boil. Appl. 2010, 30, 141–147. [Google Scholar] [CrossRef]
- Zhang, Z.X.; Sun, J.Y.; Hu, H.J.; Wang, Q.M.; Liu, X.Y. Osteoblast-like cell adhesion on porous silicon-incorporated TiO2 coating prepared by micro-arc oxidation. J. Biomed. Mater. Res. Part B-Appl. Biomater. 2011, 97B, 224–234. [Google Scholar] [CrossRef] [PubMed]
- Durdu, S.; Aktug, S.L.; Aktas, S.; Yalcin, E.; Usta, M. Fabrication and in vitro properties of zinc-based superhydrophilic bioceramic coatings on zirconium. Surf. Coat. Technol. 2018, 344, 467–478. [Google Scholar] [CrossRef]
- Durdu, S.; Aktug, S.L.; Aktas, S.; Yalcin, E.; Cavusoglu, K.; Altinkok, A.; Usta, M. Characterization and in vitro properties of anti-bacterial Ag-based bioceramic coatings formed on zirconium by micro arc oxidation and thermal evaporation. Surf. Coat. Technol. 2017, 331, 107–115. [Google Scholar] [CrossRef]
- Li, Y.D.; Wang, W.Q.; Duan, J.T.; Qi, M. A super-hydrophilic coating with a macro/micro/nano triple hierarchical structure on titanium by two-step micro-arc oxidation treatment for biomedical applications. Surf. Coat. Technol. 2017, 311, 1–9. [Google Scholar] [CrossRef]
- Tang, W.X.; Yan, J.K.; Yang, G.; Gan, G.Y.; Du, J.H.; Zhang, J.M.; Liu, Y.C.; Shi, Z.; Yu, J.H. Effect of electrolytic solution concentrations on surface hydrophilicity of micro-arc oxidation ceramic film based on Ti6Al4V titanium alloy. Rare Met. Mater. Eng. 2014, 43, 2883–2888. [Google Scholar]
- Zhang, Y.M.; Bataillon-Linez, P.; Huang, P.; Zhao, Y.M.; Han, Y.; Traisnel, M.; Xu, K.W.; Hildebrand, H.F. Surface analyses of micro-arc oxidized and hydrothermally treated titanium and effect on osteoblast behavior. J. Biomed. Mater. Res. Part A 2004, 68A, 383–391. [Google Scholar] [CrossRef] [PubMed]
- Das, K.; Bose, S.; Bandyopadhyay, A. Surface modifications and cell–materials interactions with anodized Ti. Acta Biomater. 2007, 3, 573–585. [Google Scholar] [CrossRef] [PubMed]
- Wang, Z.W.; Li, Q.; She, Z.X.; Chen, F.N.; Li, L.Q.; Zhang, X.X.; Zhang, P. Facile and fast fabrication of superhydrophobic surface on magnesium alloy. Appl. Surf. Sci. 2013, 271, 182–192. [Google Scholar] [CrossRef]
- Wang, P.; Zhang, D.; Qiu, R.; Wan, Y.; Wu, J.J. Green approach to fabrication of a super-hydrophobic film on copper and the consequent corrosion resistance. Corros. Sci. 2014, 80, 366–373. [Google Scholar] [CrossRef]
- Cui, X.J.; Lin, X.Z.; Liu, C.H.; Yang, R.S.; Zheng, X.W.; Gong, M. Fabrication and corrosion resistance of a hydrophobic micro-arc oxidation coating on AZ31 Mg alloy. Corros. Sci. 2015, 90, 402–412. [Google Scholar] [CrossRef]
- Bayati, M.R.; Molaei, R.; Kajbafvala, A.; Zanganeh, S.; Zargar, H.R.; Janghorban, K. Investigation on hydrophilicity of micro-arc oxidized TiO2 nano/micro-porous layers. Electrochim. Acta 2010, 55, 5786–5792. [Google Scholar] [CrossRef]
- Pereira, M.M.; Kurnia, K.A.; Sousa, F.L.; Silva, N.J.O.; Lopes-da-Silva, J.A.; Coutinhoa, J.A.P.; Freire, M.G. Contact angles and wettability of ionic liquids on polar and non-polar surfaces. Phys. Chem. Chem. Phys. 2015, 17, 31653–31661. [Google Scholar] [CrossRef] [Green Version]
- Kokubo, T. Bioactive glass ceramics: Properties and applications. Biomaterials 1991, 12, 155–163. [Google Scholar] [CrossRef]
- Leon, A.; Reuquen, P.; Garin, C.; Segura, R.; Vargas, P.; Zapata, P.; Orihuela, P.A. FTIR and raman characterization of TiO2 nanoparticles coated with polyethylene glycol as carrier for 2-methoxyestradiol. Appl. Sci. 2017, 7, 49. [Google Scholar] [CrossRef]
- Chellappa, M.; Anjaneyulu, U.; Manivasagam, G.; Vijayalakshmi, U. Preparation and evaluation of the cytotoxic nature of TiO2 nanoparticles by direct contact method. Int. J. Nanomed. 2015, 10, 31–41. [Google Scholar]
- Khan, M.; Naqvi, A.H.; Ahmad, M. Comparative study of the cytotoxic and genotoxic potentials of zinc oxide and titanium dioxide nanoparticles. Toxicol. Rep. 2015, 2, 765–774. [Google Scholar] [CrossRef]
- Ślósarczyk, A.; Paszkiewicz, Z.; Paluszkiewicz, C. FTIR and XRD evaluation of carbonated hydroxyapatite powders synthesized by wet methods. J. Mol. Struct. 2005, 744–747, 657–661. [Google Scholar]
- Rapacz-Kmita, A.; Paluszkiewicz, C.; Ślósarczyk, A.; Paszkiewicz, Z. FTIR and XRD investigations on the thermal stability of hydroxyapatite during hot pressing and pressureless sintering processes. J. Mol. Struct. 2005, 744–747, 653–656. [Google Scholar] [CrossRef]
- Nayak, Y.; Rana, R.; Pratihar, S.; Bhattacharyya, S. Low-temperature processing of dense hydroxyapatite–zirconia composites. Int. J. Appl. Ceram. Technol. 2008, 5, 29–36. [Google Scholar] [CrossRef]
- Kim, H.-W.; Noh, Y.-J.; Koh, Y.-H.; Kim, H.-E.; Kim, H.-M. Effect of CaF2 on densification and properties of hydroxyapatite–zirconia composites for biomedical applications. Biomaterials 2002, 23, 4113–4121. [Google Scholar] [CrossRef]
- Basar, B.; Tezcaner, A.; Keskin, D.; Evis, Z. Improvements in microstructural, mechanical, and biocompatibility properties of nano-sized hydroxyapatites doped with yttrium and fluoride. Ceram. Int. 2010, 36, 1633–1643. [Google Scholar] [CrossRef]
- Rintoul, L.; Byrne, E.W.; Suzuki, S.; Grondahl, L. FT–IR spectroscopy fluoro–substituted hydroxyapatite: Strengths and limitations. J. Mater. Sci. Mater. Med. 2007, 18, 1701–1709. [Google Scholar] [CrossRef]
- Aykul, A. Investigation of Effect of Yttrium Fluoride on Microstructural and Mechanical Properties of Hydroxyapatite and Partially Stabilized Zirconia Composites. Master’s Thesis, Gebze Institute of Technology, Gebze, Turkey, January 2010. [Google Scholar]
- Aktuğ, S.L.; Durdu, S.; Yalçın, E.; Çavuşoğlu, K.; Usta, M. Bioactivity and biocompatibility of hydroxyapatite-based bioceramic coatings on zirconium by plasma electrolytic oxidation. Mater. Sci. Eng. C 2017, 71, 1020–1027. [Google Scholar] [CrossRef]
- Aktuğ, S.L.; Durdu, S.; Yalçın, E.; Çavuşoğlu, K.; Usta, M. In vitro properties of bioceramic coatings produced on zirconium by plasma electrolytic oxidation. Surf. Coat. Technol. 2017, 324, 129–139. [Google Scholar] [CrossRef]
- Durdu, S.; Deniz, Ö.F.; Kutbay, I.; Usta, M. Characterization and formation of hydroxyapatite on Ti6Al4V coated by plasma electrolytic oxidation. J. Alloy. Compd. 2013, 551, 422–429. [Google Scholar] [CrossRef]
- Pecheva, E.V.; Pramatarova, L.D.; Maitz, M.F.; Pham, M.T.; Kondyuirin, A.V. Kinetics of hydroxyapatite deposition on solid substrates modified by sequential implantation of Ca and P ions—Part I. FTIR and raman spectroscopy study. Appl. Surf. Sci. 2004, 235, 176–181. [Google Scholar] [CrossRef]
- Shaltout, A.A.; Allam, M.A.; Moharram, M.A. FTIR spectroscopic, thermal and xrd characterization of hydroxyapatite from new natural sources. Spectrochim. Acta Part A-Mol. Biomol. Spectrosc. 2011, 83, 56–60. [Google Scholar] [CrossRef] [PubMed]
- Meskinfam, M.; Sadjadi, M.; Jazdarreh, H. Synthesis and characterization of surface functionalized nanobiocomposite by nano hydroxyapatite. Int. J. Mater. Metall. Eng. 2012, 6, 192–195. [Google Scholar]
- Aktug, S.L.; Kutbay, I.; Usta, M. Characterization and formation of bioactive hydroxyapatite coating on commercially pure zirconium by micro arc oxidation. J. Alloy. Compd. 2017, 695, 998–1004. [Google Scholar] [CrossRef]
- Müller, L.; Müller, F.A. Preparation of SBF with different content and its influence on the composition of biomimetic apatites. Acta Biomater. 2006, 2, 181–189. [Google Scholar] [CrossRef] [PubMed]
- Li, H.; Khor, K.A.; Cheang, P. Properties of heat-treated calcium phosphate coatings deposited by high-velocity oxy-fuel (hvof) spray. Biomaterials 2002, 23, 2105–2112. [Google Scholar] [CrossRef]
- Song, W.H.; Jun, Y.K.; Han, Y.; Hong, S.H. Biomimetic apatite coatings on micro-arc oxidized titania. Biomaterials 2004, 25, 3341–3349. [Google Scholar] [CrossRef]
- Li, P.J.; Kangasniemi, I.; Degroot, K.; Kokubo, T. Bonelike hydroxyapatite induction by a gel-derived titania on a titanium substrate. J. Am. Ceram. Soc. 1994, 77, 1307–1312. [Google Scholar] [CrossRef]
- Hu, C.H.; Xia, M.S. Adsorption and antibacterial effect of copper-exchanged montmorillonite on escherichia coli k-88. Appl. Clay Sci. 2006, 31, 180–184. [Google Scholar] [CrossRef]
- Ohsumi, Y.; Kitamoto, K.; Anraku, Y. Changes induced in the permeability barrier of the yeast plasma-membrane by cupric ion. J. Bacteriol. 1988, 170, 2676–2682. [Google Scholar] [CrossRef]
- Dan, Z.G.; Ni, H.W.; Xu, B.F.; Xiong, J.; Xiong, P.Y. Microstructure and antibacterial properties of AISI 420 stainless steel implanted by copper ions. Thin Solid Films 2005, 492, 93–100. [Google Scholar] [CrossRef]
- Theivasanthi, T.; Alagar, M. Studies of copper nanoparticles effects on micro-organisms. Ann. Biol. Res. 2011, 2, 368–373. [Google Scholar]
- Ramyadevi, J.; Jeyasubramanian, K.; Marikani, A.; Rajakumar, G.; Rahuman, A.A. Synthesis and antimicrobial activity of copper nanoparticles. Mater. Lett. 2012, 71, 114–116. [Google Scholar] [CrossRef]
- Trapalis, C.C.; Kokkoris, M.; Perdikakis, G.; Kordas, G. Study of antibacterial composite Cu/SiO2 thin coatings. J. Sol-Gel Sci. Technol. 2003, 26, 1213–1218. [Google Scholar] [CrossRef]
- Wang, Q.; Larese-Casanova, P.; Webster, T.J. Inhibition of various gram-positive and gram-negative bacteria growth on selenium nanoparticle coated paper towels. Int. J. Nanomed. 2015, 10, 2885–2894. [Google Scholar]

| Electrolyte | Treatment Time (min) | Applied Power (µF) | The Sizes (mm3) | Current Density (A/cm2) | Average Thickness (µm) | Average Roughness (µm) |
|---|---|---|---|---|---|---|
| Na3PO4, KOH, Distilled water | 5 | 150 | 60 × 25 × 5 | 0.325 | 60.0 ± 1.0 | 1.07 |
| Elements | The MAO Coating | The Cu-Based MAO Coating | ||
|---|---|---|---|---|
| wt.% | at.% | wt.% | at.% | |
| O | 34.82 | 60.03 | 33.06 | 58.23 |
| P | 7.76 | 6.91 | 8.53 | 7.76 |
| Ti | 57.42 | 33.06 | 55.94 | 32.91 |
| Cu | – | – | 2.48 | 1.10 |
| The Droplet’ Contacting Time (s) | The Contact Angle Values of the Substrates (°) | |
|---|---|---|
| MAO Coating | Cu-Based MAO Coating | |
| 0 | 93.9 | 94.1 |
| 10 | 86.8 | 85.3 |
| 20 | 85.2 | 82.9 |
| 30 | 84.3 | 81.5 |
| 40 | 83.8 | 80.4 |
| 50 | 83.1 | 79.8 |
| 60 | 82.9 | 79.2 |
| 70 | 82.4 | 78.8 |
| 80 | 81.9 | 78.2 |
| 90 | 81.4 | 77.6 |
| Elements | The MAO Coating | The Cu-Based MAO Coating | ||
|---|---|---|---|---|
| wt.% | at.% | wt.% | at.% | |
| O | 43.82 | 68.48 | 37.88 | 63.15 |
| P | 7.28 | 5.88 | 7.27 | 6.26 |
| Ca | 1.27 | 0.79 | 0.85 | 0.56 |
| Ti | 47.63 | 24.86 | 53.73 | 29.91 |
| Cu | – | – | 0.27 | 0.11 |
| Peak Number | Wavenumber (cm−1) | Band Assignment | Band Mode | Phase Structures | References |
|---|---|---|---|---|---|
| 1 | 560 | PO43− | Stretching | Apatite | [81,82,83] |
| 2 | 962 | PO43− | Stretching | Apatite, TCP | [83,84,85,86,87] |
| 3 | 1026 | PO43− | Stretching | Apatite | [83,84,85,86] |
| 4 | 1050 | PO43− | Stretching | Apatite, TCP | [83,84,85,86,87] |
| 5 | 1403 | C–C | Stretching | TiO2 | [43,78,79,80] |
| 6 | 1420–1425 | CO32− | Stretching | A-type apatite | [22,95] |
| 7 | 1460–1465 | CO32− | Stretching | B-type apatite | [22,95] |
| 8 | 1641 | OH− | Stretching | TiO2 | [43,78,79] |
| 9 | 1980 | P–H | Stretching | Apatite | [88,89,90,91,92,93] |
| 10 | 2302–2388 | P–H | Stretching | Apatite | [88,89,90,91,92,93] |
| 11 | 3397–3448 | Ti–O–Ti | Stretching | TiO2 | [43,78,79,80] |
| 12 | 3640–3742 | OH− | Stretching | Apatite | [88,91,92,93,94] |
© 2018 by the author. Licensee MDPI, Basel, Switzerland. This article is an open access article distributed under the terms and conditions of the Creative Commons Attribution (CC BY) license (http://creativecommons.org/licenses/by/4.0/).
Share and Cite
Durdu, S. Characterization, Bioactivity and Antibacterial Properties of Copper-Based TiO2 Bioceramic Coatings Fabricated on Titanium. Coatings 2019, 9, 1. https://doi.org/10.3390/coatings9010001
Durdu S. Characterization, Bioactivity and Antibacterial Properties of Copper-Based TiO2 Bioceramic Coatings Fabricated on Titanium. Coatings. 2019; 9(1):1. https://doi.org/10.3390/coatings9010001
Chicago/Turabian StyleDurdu, Salih. 2019. "Characterization, Bioactivity and Antibacterial Properties of Copper-Based TiO2 Bioceramic Coatings Fabricated on Titanium" Coatings 9, no. 1: 1. https://doi.org/10.3390/coatings9010001






